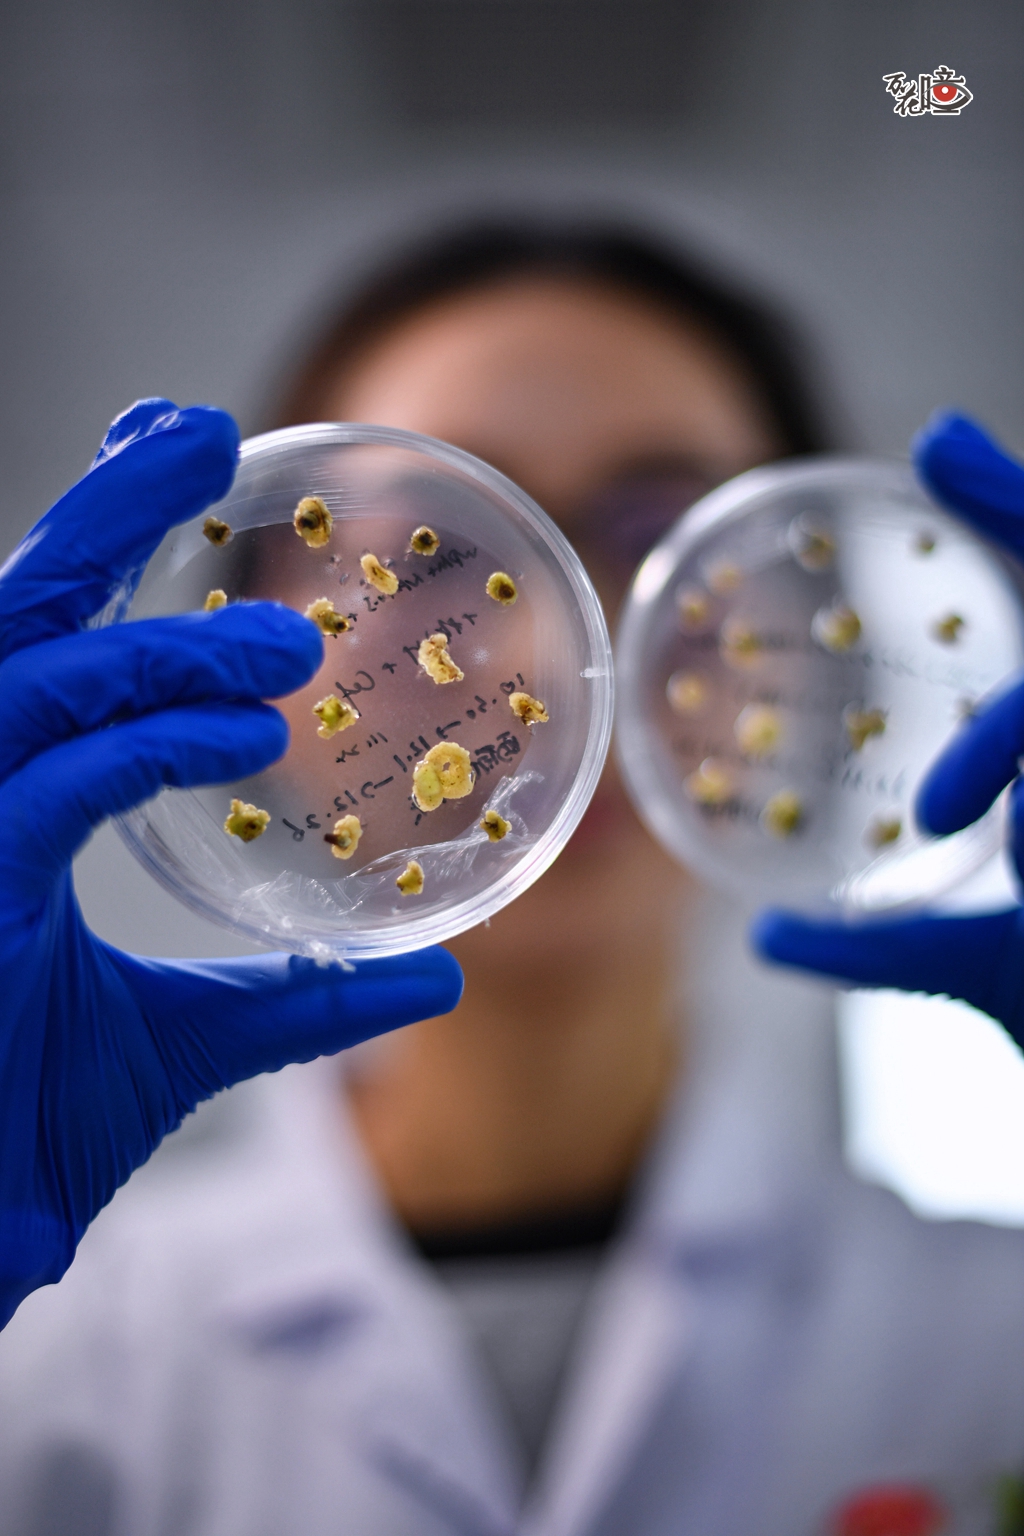

记者手记
以科技笔触,书写一朵花与一座城的四季之约。

在川渝共建乡土植物种质创新与利用重庆市重点实验室的“秘密花园”,每一株含苞的山茶,都藏着一个关于时间的愿望——让种质突破基因限制,花期越过冬春,绵延四季,在花影与数据的交错间,科研人员正书写一朵花与一座城的约定。

山茶,这朵被称为山城“市花”的冬日精灵,在11月至次年4月间凌寒绽放。而在实验室的培养箱中,一个由光与温度精密构筑的“微缩天地”悄然运转,恒温20℃的空间里,光照模拟着昼夜更迭,为山茶扦插小苗营造出适宜生长的环境,一株株嫩苗正在奋力生长。
每一个山茶细胞,都蕴藏着长成完整植株的生命蓝图。从提取、转化到基因重塑,科研人员将目标基因精准嵌入,在富含养分的培养基上,细胞开始悄然分裂、分化、萌发新芽、伸展根系。看似简单的幼苗生长过程,却需要跨越基因调控、萌芽生根等多重技术壁垒。

在洁净的无菌操作台前,科研人员呵护着这些悄然生长的绿意,他们细察组织的呼吸与生长,将跃动着生命力的部分,移入崭新的培养基中。每一次移植,都是确保每一株幼苗能在养分的浸润中,迎来完整绽放。

团队自主研究的“胚胎拯救”和“体细胞胚胎发生途径”技术,成功破解了山茶杂交育种中“种子败育”难题。实验室种质创新负责人吕志远介绍,这项技术把原本会败育的未成熟杂交种子“抢救”出来,在实验室里培育成苗,将育种周期缩短到5至8年。目前,团队已经完成西南红山茶全基因组测序,收集了900多种山茶资源,获创新种质材料880个。种质创新的突破,为城市绿化、生态修复提供了更多可能,让山茶的芬芳融入到城市的每一个角落。

实验室中整齐陈列的组培瓶里“住”着由体细胞胚胎发育而来的幼苗,那些纤柔的须根在水中轻轻舒展。以西南红山茶为例,它的花瓣能从纯白渐次浸染为深粉,实验室解码花色变化背后的调控机制,锁定关键基因。未来,借助不断优化的山茶遗传转化体系,如同为生命“编程”,定向描绘一朵花的颜色、塑造它的姿态,甚至绽放的时序。

过去,一花一木的生长皆仰赖天时,所谓“栽花种树,靠天吃饭”。而今天,科研人员已能触摸它们的生命密码,为植物“重写时序”。科研人员周玲、王娇静立苗架前,看着这些日夜悉心照料的嫩芽,就像看到自己的孩子一样,慢慢长大成人,看到这一切,幸福和欣慰感便油然而生。

放眼望去,基地中一株株山茶在田间随风摇曳,有川山茶、茶梅、四季山茶、金花茶等。山茶的颜色远不止那抹为人熟知的飒爽红,有的粉若初霞,有的白似新雪,花形也各有姿态,或重瓣层叠,或单瓣清简,更有瓣上缀着星点斑痕,描着浅淡条纹。这一切丰富的形态与色彩,并非偶然,它们凝结着基因的崭新讯息,是科研与时光共同雕琢的美。

试验田里,从盛夏到严寒,从晨昏到日落,科研人员手持尺子,俯身度量每一株育种苗的变化,新抽的枝长了多少,初绽的苞又添了几重,这些数字,成为科研的重要支撑。

一片花海中,科研人员李雪梅正进行山茶花的杂交育种,只见她指尖轻触饱满的花苞,选定作为“母亲”的花苞后细心剪开,再将从其他山茶上取来的花粉,轻轻点缀在花柱上,用锡纸包裹好花柱,再用细纱袋包好整个花苞,防止其他花粉进入到柱头内,最后挂上标识卡,整个杂交便完成了。随着时间的推移,花粉萌发产生花粉管,花粉管沿花柱进入胚囊,最终结出杂交新种子。

从重庆人记忆里的那抹冬日暖色,到点缀城区街角的“城市彩妆”,山茶始终静静述说着这座城的温度与精神。实验室中,山茶花分子育种的步伐也正加快,山茶花色、花期、抗逆性机制渐渐被改写,曾经的“季节限定”即将成为过往。未来三年内,重庆有望实现一年四季可赏山茶花。

历经一轮轮田野调查、资源采集与精心培育,1300余种川渝地区乡土植物被收集保存。除山茶之外,一批颜值能打、生存技能拉满的植物,正陆续进驻大街小巷,提升着城市的颜值,比如重庆鸢尾、垂序马蓝等品种。未来,更多承载着“重庆基因”的草木花卉,将持续融入城市的呼吸与肌理,在巴山蜀水间书写“推窗见绿、四季有花”的民生答卷。
第1眼TV-华龙网 李舒/文 刘润 李一鸣 实习生 谢雨欣/图片、视频 魏薇/美编 冯珊 李文科/主持 刘颜 董进/监制
扫一扫在手机打开当前页